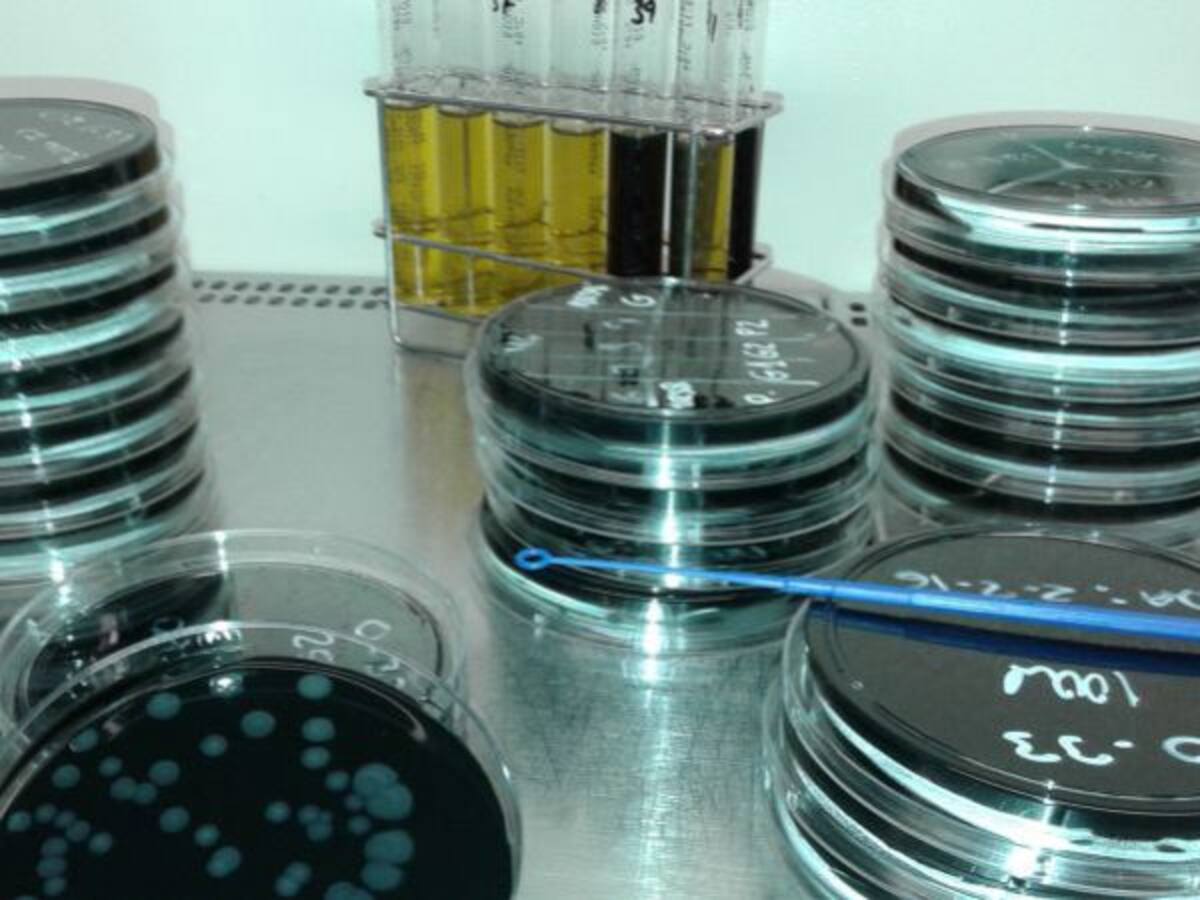

© Sociedad Española de Radiodifusión, S.L.U. 2026. Todos los derechos reservados
© Quedan reservados todos los derechos tanto sobre programas radiofónicos y las obras y prestaciones que formen parte de ellos, como sobre los contenidos publicados en esta página web. Sociedad Española de Radiodifusión SLU ejerce la oposición expresa frente al uso de sus obras y prestaciones en la elaboración de revistas de prensa prevista en el artículo 32.1 del TRLPI. Sociedad Española de Radiodifusión SLU realiza la reserva expresa frente la reproducción, distribución y comunicación pública de sus trabajos y artículos sobre temas de actualidad prevista en el artículo 33.1 del TRLPI, asimismo, también realiza una reserva expresa de las reproducciones y usos de las obras y otras prestaciones accesibles desde este sitio web a medios de lectura mecánica u otros medios que resulten adecuados a tal fin de conformidad con el artículo 67.3 del Real Decreto - ley 24/2021, de 2 de noviembre, así como frente a cualquier utilización de sus contenidos por tecnologías de inteligencia artificial, sea cual sea su naturaleza y finalidad.